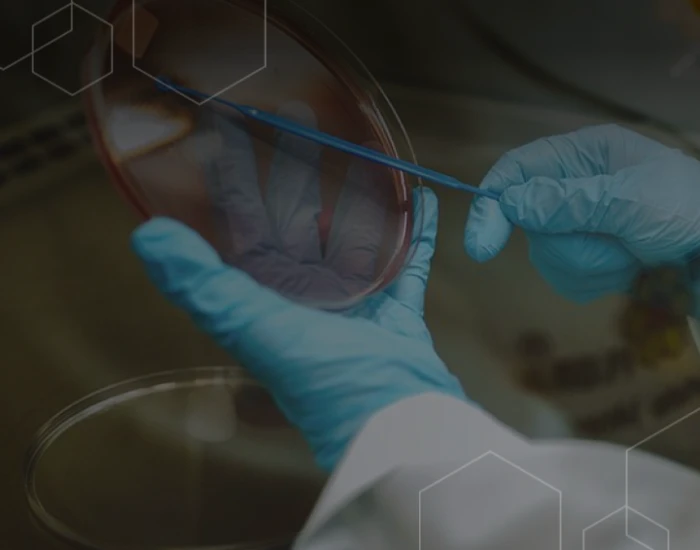

Search
Every procedure to ensure quality and safety are rigidly and rigorously followed in the preparation of the EPP-AF® propolis extract, because we want to deliver you what’s best.
Therefore, Apis Flora’s analytical guarantees for the EPP-AF® involve traditional parameters, such as total flavonoids and phenolic compounds, which are widely known substances. But it goes beyond that, because Apis Flora ensures the specific EPP-AF® active compounds, substances responsible for the batch-to-batch reproducibility of the product and for its important biological activities: caffeic acid, p-Coumaric acid, cinnamic acid, aromadendrin, Isosakuranetin and Artepillin C, among others, which are appraised with highly sophisticated equipment, such as the high performance liquid chromatography (HPLC).



In addition to the parameters above, carried out in each produced batch, microbiological quality controls are performed, which means that every batch released fulfill the most rigorous quality criteria in relation to total bacteria, fungi and yeast, and absence of pathogenic microorganisms.
Another guarantee is the absence of contaminants, such as residues, pesticides and heavy metals.
Apis Flora has more than 30 non-clinical and clinical studies done with EPP-AF® extract, which ensure that the product is 100% safe, whether in acute or chronic use.
Apis Flora works under rigorous quality standards, from the field processing stages to the product’s finishing. In other words, we are careful with a set of factors that are indispensable so that our product quality is reached, within the highest socio-environmental parameters.
